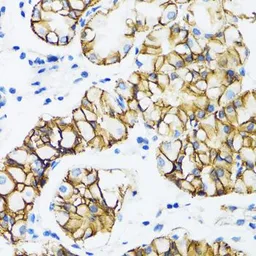

alpha 1 Catenin antibody
Cat. No. GTX32433
Cat. No. GTX32433
-
HostRabbit
-
ClonalityPolyclonal
-
IsotypeIgG
-
ApplicationsWB IHC-P IP
-
ReactivityHuman, Mouse, Rat